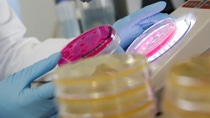
In the Research & Development Center for Biologicals at Limburgerhof, the primary focus is on living organisms such as bacteria, fungi or beneficial. Their properties are evaluated with regard to their ability of protecting plants. Due to the combination of chemical and biological agricultural solutions, farmers can give their crops a broader protection from diseases and insect pests, provide better management of resistance and residues, and deliver improved crop quality and yield potential.
The shelf life is significant for the research of new biologicals. Deborah Lynn Neethling, researcher at BASF in the area of Microbiology & Biologicals Strain Library, and Christina Arends, laboratory chemist, establish the CFU-values (CFU stands for colony forming units), thus the amount of fungal or bacteria colonies in biological formulations. The number of colonies on a plate depicts the concentration of the active ingredient in the product. Testing this over time ensures the biological is active for the duration of its shelf-life. In the Research & Development Center for Biologicals at Limburgerhof, the primary focus is on living organisms such as bacteria, fungi or beneficial. Their properties are evaluated with regard to their ability of protecting plants. Due to the combination of chemical and biological agricultural solutions, farmers can give their crops a broader protection from diseases and insect pests, provide better management of resistance and residues, and deliver improved crop quality and yield potential.
The shelf life is significant for the research of new biologicals. Deborah Lynn Neethling, researcher at BASF in the area of Microbiology & Biologicals Strain Library, and Christina Arends, laboratory chemist, establish the CFU-values (CFU stands for colony forming units), thus the amount of fungal or bacteria colonies in biological formulations. The number of colonies on a plate depicts the concentration of the active ingredient in the product. Testing this over time ensures the biological is active for the duration of its shelf-life.

Organization
Agricultural Specialities
BASF Agricultural Specialities is a leading manufacturer of bio-pesticides and inoculants. Located in Durban, the plant has been in existence since 1995. The purpose built production plant supplies the agricultural market in South Africa, the rest of Africa and globally. The state of the art laboratory allows for routine monitoring of all incoming raw material, in process and final product quality control. These analyses check for conformance with specification in terms of the levels of active ingredient, viability, shelf life, absence of unwanted contaminants, moisture content and particle size to ensure quality product.
91 Clifton Canyon Drive
Clifton Farm
MAHOGANY RIDGE
3610
Telephone +27 31 769-2003